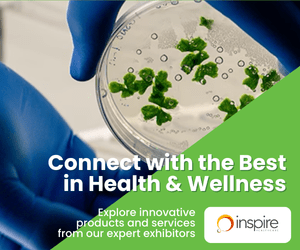

Health & Wellness Fiesta
1-3 May 2026
Suntec Convention Centre
FREE ADMISSION
LeveL 4, Hall 401-402
11am -9pm daily




Live Better.
Look Brighter.
Rediscover your best self at Health and Wellness Fiesta 2026, Singapore’s leading event dedicated to wellness, beauty, fitness, nutrition and healthy living. Taking place over three exciting days, this vibrant showcase brings together the latest trends, products and innovations all in one inspiring space.
Whether you are passionate about self-care, exploring a healthier lifestyle, or simply curious about the newest wellness solutions, there is something here for everyone.
Enjoy interactive workshops, expert-led talks, exclusive promotions, onsite health screenings and more than 100 curated wellness and beauty brands from across the region.
Come be part of the future of wellness — and start your journey to a healthier, happier you.